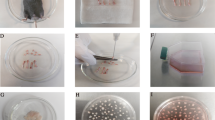

Abstract
Objective
The goal of this study is to examine if allogenic mesenchymal stem cell (MSC) transplantation is a useful therapy for left ischemic colon anastomosis in rats.
Summary and background data
Problems with anastomosis healing may lead to serious postoperative complications. Bone marrow-derived mesenchymal stem cells (BM-MSCs), which are also referred to as stromal progenitor cells, are self-renewing and expandable stem cells. Recent studies have suggested that BM-MSCs play a crucial role in the processes of intestinal repair and accelerate angiogenesis.
Methods
MSCs were isolated from rats before analysis by light and scanning electron microscopy. Forty male Wistar albino rats weighing 250–280 g were divided into four equal groups (n = 10) as follows: group 1: control, ischemic left colonic anastomoses (fourth day); group 2: control, ischemic left colonic anastomoses (seventh day); group 3: ischemic left colonic anastomoses + locally transplanted BM-MSCs (fourth day); group 4: ischemic left colonic anastomoses + locally transplanted BM-MSCs (seventh day). Histopathological features and anastomotic strength were evaluated.
Results
BM-MSCs therapy significantly accelerated all of the healing parameters for ischemic colonic anastomosis except for inflammation on the fourth day. On the seventh day, BM-MSCs augmented the levels of the hydroxyproline and bursting pressure. Histological parameters, especially angiogenesis, were also found to be important for healing of ischemic colonic anastomoses.
Conclusions
This is the first study to use locally transplanted cell therapy for the healing of ischemic colonic anastomosis. BM-MSCs therapy significantly accelerated all of the healing parameters for ischemic colonic anastomosis.
Similar content being viewed by others
Avoid common mistakes on your manuscript.
Introduction
Problems with anastomosis healing may lead to serious postoperative complications. Healing of intestinal anastomoses and, in particular, the development of early postoperative anastomotic strength may be compromised by numerous technical, local, and systemic factors [1, 2]. A major surgical problem, dehiscence following colorectal surgery is a significant cause of morbidity and mortality. The rate of clinically apparent anastomotic leakage ranges from 3.4% to 8%. At least one third of deaths following colorectal surgery are attributed to anastomotic leakage [3]. Dehiscence of intestinal anastomoses is mostly seen during the first week postsurgery [2]. Ischemia is one of the most important reasons that contribute to the dehiscence of intestinal anastomoses [4]. After gastrointestinal surgery, many instances of leakage during clinical situations (tension sutures and excessive devascularization of the ends) exhibit hypoperfusion of anastomoses. If the degree of hypoxia is enough to interfere with tissue viability, then tissues necrose, thereby resulting in delayed wound healing [5]. Ischemic wounds heal poorly and infect easily. Preventing or reducing the ischemic damage is one of the goals of the surgical procedures [4].
Bone marrow-derived mesenchymal stem cells (BM-MSCs), which are also referred to as stromal progenitor cells, are self-renewing and expandable stem cells. BM-MSCs from several sites, including bone marrow and adipose tissue, may have immunomodulatory properties, thereby indicating a possible use for BM-MSCs in regenerative medicine and tissue engineering [6–9]. BM-MSCs have the ability to differentiate into several cell types, including osteoblasts, chondroblasts, fibroblasts, adipocytes, skeletal myoblasts, cardiomyocytes, and endothelial cells [7, 10]. In contrast to hematopoietic stem cells, BM-MSCs are abundant in bone marrow and are easy to harvest and expand in vitro, which makes them a desirable cell type for autologous regenerative cell therapy [7, 11]. These properties allow BM-MSCs to be an autologous cell source, which in some cases circumvents host immune responses and makes them a good candidate for potential therapeutic applications such as cellular and gene therapies, tissue engineering, small animal model-based vascular biology studies, in vivo imaging techniques, and other preclinical investigations [12]. Recent studies have suggested that BM-MSCs play a crucial role in the processes of intestinal repair [13] and accelerate angiogenesis [14].
In this study, we aimed to investigate the role of the mesenchymal stem cells in the early phase of wound healing of left ischemic colon anastomosis in rats.
Materials and methods
Isolation and preparation of BM-MSCs
Animals
Wistar albino rats (male, 8 weeks old) were obtained from the Experimental Animal Center of Kocaeli University (Kocaeli-TURKIYE). The animal housing and experiments were approved by the local animal care committee according to the institutional guidelines and national animal welfare act.
Isolation and culturing of BM-MSCs
To establish the BM-MSCs cultures, the animals were sacrificed under anesthesia. Then, under sterile conditions, both the femurs and tibiae were excised and cut away. Then, a 21-gauge needle that was inserted into the shaft of the bone and marrow was extruded by flushing with MEM-Eagle medium (Biochrom, Berlin, Germany) supplemented with 15% fetal bovine serum (Invitrogen/GIBCO, Grand Island, NY, USA), as well as 100 IU/ml penicillin and 100 μg/ml streptomycin (Invitrogen/GIBCO) that was included in the growth medium. The marrow plug suspension was dispersed by pipetting, successively filtered through a 70-μm mesh nylon filter (BD Biosciences, Bedford, MA, USA), and centrifuged at 200 ×g for 10 min. The supernatant containing thrombocytes and erythrocytes was discarded, and the cell pellet was resuspended in the medium. The cells from one rat were seeded onto two 25-cm2 plastic tissue culture flasks (BD Biosciences) and incubated at 37°C in a humidified atmosphere containing 5% CO2 for 3 days. The mesenchymal stem cells were isolated on the basis of their ability to adhere to the culture plates. On the third day, red blood cells and other non-adherent cells were removed and fresh medium was added to allow further growth. The adherent cells were grown to 70% confluency and were defined as passage zero (P0) cells. The P0 MSCs were washed with Ca2+–Mg2+ free phosphate-buffered saline (PBS) (Invitrogen/GIBCO) and detached by incubating with 0.25% trypsin-EDTA solution (Invitrogen/GIBCO) for 5–10 min at 37°C. Complete medium was added to inactivate the trypsin. The cells were centrifuged at 200 ×g for 10 min, resuspended in 1 ml complete medium, counted manually in duplicate using a Thoma chamber, then plated as P1 in 75-cm2 flasks (BD Biosciences) at a density of 1 × 106 cells/flask. Complete medium was replaced every third day over a 10–14-day period. For each passage, the cells were plated similarly and grown to 70% confluency.
Characterization studies of BM-MSCs
Phenotype identification
Flow cytometry
To confirm that BM-MSCs maintain their phenotypic characteristics after growth in culture, undifferentiated MSCs were subjected to flow cytometry analysis. Flow cytometry was performed on a FACS Calibur and the data were analyzed with the Cell Quest software. Immunophenotyping of rBM-MSCs was performed with antibodies against rat antigens CD29 (Integrin β1 chain; Ha2/5; FITC), CD45, and CD90 (Thy-1/Thy-1.1-FITC), as well as their isotype controls (IgG2a K; FITC) (BD Biosciences, San Diego, USA).
Cell staining
Immunofluorescence staining was used for determining the expressed protein profiles using fluorescence dye-attached antibodies (FITC, Texas red). In immunochemistry staining, rather than utilizing fluorescence dye-attached antibodies, HRP-conjugated antibodies were used. Hisopathological/immunohistochemical examination was used to examine the protein profiles in embedded tissues. Immunofluorescence and immunocytochemistry analyses were performed according to a previous report [12]. The primary antibodies used in the studies were indicated in Table 1.
Immunohistochemistry
For identifying cell characteristics, cells from P0, P1, P3, P4, and P5 were seeded on poly-l-lysine coated eight-well chamber slides (BD Biosciences), cultivated for another 2 days, and subjected to immunocytochemistry and immunofluorescence studies.
Immunofluorescence staining
Samples were rinsed briefly in PBS, fixed in ice-cold methanol for 10 min, and then allowed to dry completely. After being permeabilized with 0.025% Triton X-100 (Merck, Darmstadt, Germany), the cells were incubated with 1.5% normal goat or donkey blocking serum (Santa Cruz Biotechnology) in PBS for 30 min at 37°C to suppress the non-specific binding of IgG. After washing the cells three times with PBS (5 min each), the cells were incubated overnight at 4°C with the primary antibodies listed in Table 1. After three changes of PBS washes, the cells were incubated with FITC and appropriate secondary antibodies were labeled with Texas red (Santa Cruz Biotechnology) for 25 min in the dark. After washing three times with PBS in the dark, the cells were mounted with a mounting medium containing DAPI (Santa Cruz Biotechnology).
Immunocytochemistry staining
Immunocytochemistry analysis was performed using the streptavidin–peroxidase method (UltraVision Plus Large Volume Detection System Anti-Polyvalent, HRP immunostaining Kit, Thermo Scientific, UK). To reduce nonspecific background staining due to endogenous peroxidase, the cultured cells were fixed in ice-cold methanol with 0.3% hydrogen peroxide (Carlo Erba Reactifs, Val-De-Reuil Cedex Pa Des Portes, France) for 15 min and allowed to dry. After additional PBS washes, the cells were incubated with Ultra V Block for 5 min at room temperature. The cells were then incubated overnight at 4°C with the primary antibodies listed in Table 1. The following day, the cells were incubated with biotinylated secondary antibodies for 15 min at room temperature. The incubations were followed by streptavidin–peroxidase treatment for 15 min at room temperature and detection of the signal was completed with an AEC kit (Zymed Laboratories, UK). Counter-staining was done with hematoxylin (Santa Cruz Biotechnology). The mounted cells were examined under a fluorescence microscope (Leica DMI 4000B, Wetzlar, Germany).
Cell labeling
BM-MSCs were plated at a density of 1 × 106 cells into T75 flasks and incubated for 2 days until they reached 50% confluence. The medium was changed with the same medium containing 10 mM of BrdU (Sigma, St. Louis, USA). After 48 h of incubation at 37°C and 5% CO2, the BrdU-labeled MSCs were trypsinized and evaluated for viability.
Study design
This part of the study was completed in the Department of Experimental Medicine at the Research Institute of Istanbul University. The study protocol was approved by the Institutional Animal Care and Use Committee at Istanbul University. Forty male Wistar albino rats weighing 250–280 g were divided into four equal groups (n = 10). The animals were housed at 21°C and were given tap water and standard rat food. Group 1 and group 3 rats were killed 4 days after surgery. In group 2 and group 4, these were sacrificed 7 days after the surgical procedure.
-
Group 1:
control, ischemic left colonic anastomoses (fourth day)
-
Group 2:
control, ischemic left colonic anastomoses (seventh day)
-
Group 3:
ischemic left colonic anastomoses + locally transplanted BM-MSCs (fourth day)
-
Group 4:
ischemic left colonic anastomoses + locally transplanted BM-MSCs (seventh day)
Preparing for cell transplantation
The cryopreserved BrdU-labeled BM-MSCs were processed as below and then re-evaluated for cell viability before transplantation. The cells were incubated in a water-bath at 37°C and then washed with phosphate-buffered saline and Dulbecco’s Minimal Essential Medium. Cell viability was determined by a trypan blue exclusion assay. Labeled BM-MSCs were stained with trypan blue, whereby viable BM-MSCs with an intact membrane excluded trypan blue and were not stained. The viable cells were counted on a Beckman Coulter Vi-Cell XR Cell Viability Analyzer (1.0 × 106 cells in 1 ml).
Surgical procedure and cell transplantation
After one night of fasting, the animals were anesthetized by an intramuscular injection of ketamine hydrochloride (50–100 mg per kilogram of body weight). Abdominal access was achieved through a midline incision at 4 cm long, and the left colon was diverted at 3 cm proximal to the peritoneal reflection. Care was taken to preserve the marginal vessels of the colon. In order to establish ischemic colon anastomosis, the vessels in the mesocolon between 2 cm proximal and 2 cm distal from the anastomosis line were ligated. After the fecal contents had been removed, a standardized end-to-end anastomosis was made of eight interrupted, inverted sutures of 6/0 polypropylene. After the surgical procedure, group 3 and group 4 received transplanted BM-MSCs (0.5 ml, 1.0 × 106 cells) around the anastomotic area. Group 1 and group 2 (control groups) were injected with physiological serum around the anastomotic area. The bleeding control had been done; 2 cc 0.9% NaCl was injected intraperitoneally and the abdomen was closed with 3/0 continuous silk sutures. Water was given at 12 h and food was given at 24 h later.
Measurement of colonic bursting pressure
Four days (group 1 and group 3) and seven days (group 2 and group 4) later, all of the rats were sacrificed. The abdominal incision was reopened and then the anastomotic sutures lines were recognized. The anastomotic segment was resected, preserving the adhesions that were 2 cm proximal and 2 cm distal to the anastomotic line. Bursting pressure was measured in situ without detaching the adhesions. The bursting pressure of the anastomotic segment was measured with a mercury manometer and a constant flow pump. Briefly, a 16-gauge silastic catheter was inserted via a colostomy in the proximal colon and ligated with a 2/0 silk tie. The rectum distal to the anastomosis was ligated with 2/0 silk and was continuously infused through the catheter via a tube pump at a rate of 4 ml/min. Bursting pressure was recorded (mmHg) as the peak pressure attained before the rupture of the anastomosis, which resulted in an abrupt drop in pressure.
Hydroxyproline determination
The tissue samples were excised 0.5 cm proximal and 0.5 cm distal of the anastomosis line. Then, all of the samples were weighed and homogenized in physiological serum as 20% homogenates using a Potter-type glass homogenizer (Heidolphy-RZR 2021, Germany). The homogenates were centrifuged at 1,500 r/min for 15 min and the obtained supernatants were hydrolyzed by adding equal amounts of hydrochloric acid for 10–18 h. Using a hydroxyproline kit (Hipronisticon, Organon, Holland), which was based on the principles of Stegeman and Stadler, the hydroxyproline amount was calculated in micrograms per milligram of wet tissue by reading the absorbance of the solution on a spectrometer at 560 nm.
Tissue harvesting and histopathological/immunohistochemical examinations
To determine histological and immunohistochemical assessments, the bursting colon was excised, cleared of surrounding mesentery and fat, and washed with saline. The anastomosis was excised together with 1 cm of the adjacent proximal and distal colon. The tissues were fixed in 10% formalin for approximately 24 h and then embedded in paraffin. Transverse sections of the embedded tissue that were 3 μm in thickness were stained with hematoxylin and eosin, and histological assessment was carried out without knowing the identity of the groups. Necrosis, epithelialization, inflammatory processes, fibroblastic activity, and neovascularization at the anastomic site was studied and scored (from 0 to 3: 0, none; 1, slight; 2, moderate, and 3, dense). Masson’s trichrome staining was used for distinguishing cells from the surrounding connective tissue. Three dyes were employed and solution C was used to stain the collagen. Collagen deposition was scored according to the density of the colonic tissue (from 0 to 3: 0, none; 1, slight; 2, moderate; 3, dense).
To perform cell tracing after the injection of the BrdU labeled BM-MSCs, an immunofluorescence double staining protocol was performed on the paraffin-embedded tissues. Slides were deparaffinized with two changes of xylene for 5 min each and rehydrated in a series of graded alcohol solutions. Endogenous peroxidases were inhibited by incubation with fresh 3% H2O2 in PBS buffer. The sections were then treated with a trypsin solution in a moist chamber at 37°C for 10 min. DNA was denatured by incubation with the denaturing solution. Nonspecific staining was blocked with the mixture of two different sera at 1.5% in PBS for 30 min at room temperature (RT). Afterwards, the sections were incubated in a mixture of two primary antibodies in a pair-wise fashion with the mouse monoclonal anti-BrdU antibody (Thermo Scientific MS-1058-P) and Vimentin (sc-7557 Santa Cruz) or with CD105 (sc-19793) and nestin (sc-33677) with Proliferating Cell Nuclear Antigen (PCNA) (MS-106-R7) at appropriate dilutions in antibody dilution buffer for 2 h at RT. The sections were incubated in a mixture of two fluorescent conjugated secondary antibodies, which included the goat anti-mouse TR (sc-2781) for the BRDU antibody, donkey anti-goat FITC (sc-2024) for vimentin and CD105, and goat anti-mouse FITC (sc-2010) for nestin at the dilution of 1:500 in PBS buffer for 30 min at room temperature and were mounted with the mounting medium containing DAPI (Santa Cruz Biotechnology).
Statistical analysis
Data were reported as means ± SD. All statistical analyses were performed using SPSS 16.0 for Windows. Data were analyzed using two-way ANOVA and a paired t-test. A probability value of P < 0.05 was considered to denote statistical significance.
Results
Cell culture of BM-MSC
BM-MSCs attached to the culture flasks sparsely and displayed a fibroblast-like, spindle-shaped morphology during the initial days of incubation. After 3 to 4 days of incubation, proliferation started and the cells gradually grew into small colonies. By the time they were 6 to 8 days old, different-sized colonies increased in number. As growth continued, adjacent colonies interconnected with each other, and a confluent monolayer was obtained after 12 to 15 days of incubation. In later passages, MSCs exhibited large, flattened, or fibroblast-like morphology (Fig. 1a) and did not change up to 25 passages. Tests for bacterial and mycoplasm contamination were negative, and the viability was higher than 95%. To confirm the BrdU labeling of cells, we performed immunostaining and imaged them. BrdU-labeled cells could be identified by the green staining in their nuclei seen under fluorescence microscopy (Fig. 1b, c) in addition to DAB BrdU immunostained cells with a dark gray-black color (Fig. 1d).
a rBM-MSCs (P4) exhibited large, flattened, or fibroblast-like morphology (original magnification, ×200). b, d Representative immunostaining fields are shown for BrdU by immunofluorescence (b and c) and immunocytochemical (d) techniques. The images shows the nuclear localization of BrdU in labeled cells (arrows). Scale bars: b, d 70 μm, c 50 μm
Flow cytometry identification of BM-MSCs
The general strategy for identifying in vitro-cultivated BM-MSCs was to analyze the expressions of cell surface markers such as CD29, CD44, CD90, and CD106 [15–17]. In our FACS experiments, BM-MSCs were negative for CD45, a cell surface marker associated with lymphohematopoietic cells (Fig. 2a, b). Therefore, there was no evidence of hematopoietic precursors in the cultures. In contrast, the expression of other surface antigens agreed with the previous reports regarding murine MSCs and indicated that the cells used in our study had the characteristics of MSCs reported elsewhere [15–17]
Immunocytochemical identification of BM-MSCs
Immunohistochemical studies were performed to characterize the progeny of the BM-MSCs by using a large panel of antibodies specific to known antigens associated with different phenotypes. The immunoreactivity profile for BM-MSCs is shown in Table 1.
The antigenic phenotype of MSCs is not unique and no single marker has been found to be specific for MSCs. However, in the past, certain antigens such as surface and cytoplasmic proteins have been used in attempts to characterize MSCs. The expression of some of these antigens was also examined for the rBM-MCSs of this study. Under standard culture conditions, vimentin, type I and II collagen, nestin, desmin, actin, alpha-smooth muscle actin, fibronectin, and CD105 were expressed. As indicated in Table 1, the BM-MSCs of this study did not express some surface markers including CD31 (endothelial), CD34, CD45 (hematopoietic markers), and CD71.
Cells tracing after the injection of the BrdU-labeled BM-MSCs
BrdU was used to label BMSCs and then they were transplanted around the anastomotic area. At 4 and 7 days later, we observed BrdU-labeled BM-MSCs in the stromal tissues of the recipient rats. To confirm this data, we performed double staining for CD105 which is a MSC marker, and the cells expressed both markers (Fig. 3a–d). In addition, we investigated the expression of proliferative cell nuclear antigen (PCNA) and nestin in colon tissue samples. PCNA is a marker for cells in early G1 phase and S phase of the cell cycle. Nestin is also a stem cell marker. We identified transplanted MSCs by assaying for the expression of PCNA and nestin (Fig. 3e, f).
The fluorescence views of paraffin sections from different segments of BM-MSCs transplanted groups that have undergone double staining for BrdU and CD105 (a, b group 3, transplanted stem cells on the fourth day; c, d group 4, transplanted stem cells on the seventh day) and PCNA and nestin (e group 3 and f group 4, respectively). The cells that show a positive nuclear reaction for BrdU (red) were observed in stromal tissues only (indicated by arrows) (a–d). PCNA is a marker for cells in the early G1 phase and S phase of the cell cycle. In order to trace the injected BM-MSCs, we used PCNA and nestin immunostaining in tissue sections as the secondary method. The cells that have positively stained nuclei for PCNA (red) and also positively stained cytoplasm for nestin (green) in colonic sections of both transplantation groups (e group 3, transplanted stem cells on the fourth day; f group 4, transplanted stem cells on the seventh day) were detected (indicated by arrows). Scale bars, 50 μm
Bursting pressures
The mean bursting pressures of ischemic colonic anastomoses in group 3 (transplanted cells—fourth day) were higher than in control group 1 (fourth day) (p < 0.01) (Table 2). A comparison of bursting pressures by the seventh day in group 4 (transplanted cells—fourth day) was significantly different from control group 2 (7th day) (p < 0.01) (Table 2).
Hydroxyproline contents
We found significantly higher hydroxyproline values in group 3 than in control group 1. On the seventh day, the values of hydroxyproline were significantly higher in group 4 than in control group 2. Hydroxyproline levels were increased upon transplanted stem cell therapy in group 3 and in group 4. The hydroxyproline values for all groups are given in Table 2.
Histological features
At necropsy, all of the anastomosis were severed with either omentum or small bowel loops and lacked evidence of leakage or peritonitis. We investigated the early period of wound healing (fourth and seventh day, respectively). When comparing between group 1 and group 3, we found higher levels for all of the histological parameters except inflammation in group 3 (fourth day) compared to the control group 1 (Table 3; Fig. 4a, b). On day 7, when comparing between group 2 and group 4, we found higher levels for parameters of necrosis, collagen deposition, and fibroblastic activity (Table 3; Fig. 4c, d).
a Slight inflammation and angiogenesis are seen (HE, ×40) (group 1). b Many new vessels are formed and fibroblastic activity is observed (HE, ×100) (group 3). c Slight collagen deposition is shown in the anastomotic area. The blue area is connective tissue (Masson Trichrome, ×100) (group 2). d Dence collagen deposition is shown in the anastomotic area. The blue area is connective tissue (Masson Trichrome, ×200) (group 4)
Discussion
Numerous local and systemic factors affect anastomotic healing. The most important local factor is the perfusion and oxygenation of the site of anastomosis. To achieve safe anastomosis, intestinal blood flow should exceed 30% [18]. Tissue perfusion and oxygenation decrease in ischemic condition. This situation is one of the most significant risk factor for wound healing. Adequate tissue oxygenation is required for normal oxidative function of neutrophils, leukocyte activation, fibroblast production, angiogenesis, and reepithelialization, which are all essential in wound healing [4]. The fibroblasts are the major producers of collagen in the repairing process. Hypoxia affects fibroblast activity by decreasing IGF-1 production, increasing TGF-β production, and increasing procollagen mRNA levels [19, 20]. Many substances in the literature have been investigated for their ability to eliminate tissue ischemia and ischemic consequences such as low oxygenation and perfusion deficiency. Until now, no published substance or method has been found to be effective. As a major surgical problem following colorectal surgery, anastomotic dehiscence is a significant cause of morbidity and mortality during ischemic condition. Stem cell research has received much attention in recent years and has shown positive effects on the gastrointestinal system. BM-MSCs contribute to the regeneration of mesenchymal tissues such as bone, cartilage, muscle, ligament, tendon, adipose, and stroma. In addition, they have many characteristics which make them suitable for their potential use in tissue engineering of the small intestine. For example, BM-MSCs can replicate as undifferentiated cells that have the potential to differentiate into lineages of mesenchymal tissues, they display a stable phenotype, they are immunocompatible, and they have no associated ethical issues with their use [21]. Furthermore, BM-MSCs potentially represent a novel treatment modality for the repair and regeneration of injured intestinal tissues. In preliminary laboratory and clinical investigations, autologous or allogeneic MSCs either implanted directly into injured tissue or delivered systemically via intra-arterial or intravenous infusions have resulted in significant benefits for many types of injured and diseased tissues [22]. Some studies have examined the use of BM-MSCs for the treatment of inflammatory bowel disease. Transplanted cells have been reported to improve the microcirculation of inflamed areas, which might be important for mucosal repair [14].
In the literature, there have been no studies addressing transplanted stem cell therapy for healing of ischemic colonic anastomosis. This study demonstrated that BM-MSCs engrafted safely and successfully after local injection in ischemic colonic anastomoses. The labeled cells were well distributed within the site of injection. Moreover, the study demonstrated that transplanted stem cell therapy significantly accelerated many parameters of the healing process for ischemic colonic anastomosis. The assessment of anastomic healing mainly depends on mechanical parameters, and bursting pressure is particularly valuable [4, 23]. Bursting pressures have been shown to remain low for the first three to four days [24, 25]. The lowest level of bursting pressure (median, 47.5 mmHg, 25–90 mmHg) (50.5 mmHg) was found in group 1 when compared to the other groups on the fourth postoperative day. The bursting pressure was approximately two times greater in the group of transplanted BM-MSCS (median, 100 mmHg, 60–180 mmHg) (106 mmHg) than in the controls, and this difference was statistically significant. Moreover, bursting pressure was found as statistically different in the group of transplanted BM-MSCS at postoperative day 7. When comparing all groups with each other, the highest explosion pressure was found in group 4 (median, 195 mmHg, 150–260) (199.5 mmHg). Hydroxyproline levels, which indicate collagen content, were determined. Bursting pressure and hydroxyproline levels showed that the transplanted stem cells augmented the healing process in ischemic colonic anastomoses in group 3 and in group 4. When comparing the histological parameters, collagen formation and fibroblastic activity were similar to these results. As far as we know, the amount of mechanical strength is associated with collagen and fibroblast activation in the intestinal system. The BM-MSCs transplanted groups (group 3 and group 4) showed fibroblast activation and collagen deposition that were significantly higher on the fourth and seventh day compared to controls. In the present study, BM-MSCs expressed some antigens that are known indicators of fibroblastic activity. The increased collagen production and fibroblastic activity may be due to the transplanted BM-MSCs. They may possess a unique ability to enhance intestinal cell viability and proliferation after a hypoxic injury. This enhanced viability and proliferation may be due to the release of paracrine mediators such as VEGF, hepatocyte growth factor, and IL-6 from MSCs [22]. VEGF also appears to enhance angiogenesis during acute inflammation and ischemia, and it may enhance stem cell survival during transplantation. In addition, the release of growth factors, known as angiogenetic factors, are known to make a very important contribution to collateral modeling [14].
Neovascularization is a crucial step in the wound healing process [26, 27]. Recent studies have shown that the introduction of autologous bone marrow-derived or peripheral blood-derived cells can restore tissue vascularization after ischemic events in limbs, retina, and myocardium [14]. Furthermore, it has been demonstrated that the injection of BM-MSCs into the ischemic myocardium significantly enhances the perfusion of ischemic tissue and collateral remodeling, reduces tissue damage, and improves cardiac function [7]. Tadauchi et al. showed that the introduction of BM-MSCs enhances tissue repair in the colon after injury. Their histological findings showed many transplanted BM-MSCs in the submucosa, and the capillary density score in the submucosa was higher than that in the control group [14]. In our study, histological examination showed that necrosis in the BM-MSCS-transplanted group was significantly different from the control group on postoperative days 4 and 7. In the control group (group 1), the necrosis score was the highest (2.6), while the lowest score was found to be 1.5 in group 4. This latter group was associated with newly formed capillary networks. In addition, when comparing the rates of angiogenesis, group 3 and group 4 were numerically higher. Although the differences in angiogenesis rates were statistically significant on the fourth postoperative day, these differences were not statistically significant on the seventh postoperative day in the BM-MSCs-transplanted group. The mechanism of angiogenesis may occur through the release of angiogenetic factors and the differentiation of the transplanted cells into endothelial cells [28]. Some studies have reported only occasional vessels containing transplanted cells despite impressive improvement in perfusion [14]. Brittan et al. [30] reported that bone marrow cells were involved in neovasculogenesis in the colon after induced colitis in mice [11].
A growing body of data have suggested that bone marrow contains adult somatic stem cells that are involved in the healing process after gut injury [11, 29]. However, the integration of BM-MSCs into the gastrointestinal tissue reduces after the damage has been completely healed, thereby suggesting that BM-MSCs participate positively in wound healing [11]. Hori et al. in 2001 succeeded in regenerating intestinal tissue on the luminal surface of a collagen scaffold seeded by autologous MSCs that they had applied to replace a 5-cm defect in the dog jejunum [21]. In the current study, we reported the various effects of BM-MSCS transplantation on ischemic colonic anastomosis such as the following: (a) growth factors and the organization of signals in the injured area, (b) increasing angiogenesisis in hypoxic tissue, (c) increased perfusion with a correction in the metabolic activity in the injured region, (d) perfusion with improved fibroblastic activity and collagen synthesis, and (e) increases in collagen synthesis because of stem cell conversion to fibroblast.
In conclusion, this was the first study to use locally transplanted cell therapy for the healing of ischemic colonic anastomosis. BM-MSCs therapy significantly accelerated all of the healing parameters for ischemic colonic anastomosis except for inflammation on fourth day. On the seventh day, BM-MSCs augmented the levels of the hydroxyproline and bursting pressure. Histological parameters, especially angiogenesis, were also found to be important for healing of ischemic colonic anastomoses. However, BM-MSCs did not accelerate angiogenesis on the seventh postoperative day of anastomosis.
References
Guven A, Pehlivan M, Gokpinar I, Gurleyik E, Cam M (2007) Early glutamine-enriched enteral feeding facilitates colonic anastomosis healing: light microscopic and immunohistochemical evaluation. Acta Histochem 109:122–129
Verhofstad HJM, Lange PW, van der Laak J, Verhofstad AJ, Hendriks T (2002) Microscopic analysis of anastomotic healing in the intestine of normal and diabetic rats. Dis Colon Rectum 44:423–431
Egger B, Inglin R, Zeek J, Dirsch O, Huang Y, Büchler MW (2001) Insulin like growth factor I and truncated keratinocyte growth factor accelerate healing of left sided colonic anastomoses. Br J Surg 88:90–98
Hamzaoglu I, Karahasanoglu T, Aydın S, Sahin AD, Carkman S, Sarıyar M, Alemdaroglu K (1998) The effects of hyperbaric oxygen on normal and ischemic colon anastomoses. Am J Surg 176:458–461
Garcia JG, Criado CG (1998) Healing of colonic ischemic anastomoses in the rats. Dis Colon Rectum 41:829–895
Pascual I, Miguel FG, Pinedeo-Gomez UA, Arranz GM, Olmo-Garcia D (2008) Adipose-derived mesenchymal stem cells in biosutures do not improve healing of experimental colonic anastomoses. Br J Surg 95:1180–1184
Gao F, He Tao, Wang H, Yu S, Yi D, Liu W, Cai Z (2007) A promising strategy for the treatment of ischemic heart disease: mesenchymal stem cell-mediated vascular endothelial growth factor gene transfer in rats. Can J Cardiol 23:891–898
Wu Y, Chen L, Scott GP, Tredget E (2007) Mesenchymal stem cells enhance wound healing through differentiation and angiogenesis. Stem Cells 25:2648–2659
Day MR (2006) Epithelial stem cells and tissue engineered intestine. Curr Stem Cell Res Ther 1:1113–1120
Piao H, Youn TJ, Kwon JS (2005) Effects of bone marrow derived mesenchymal stem cells transplantation in acutely infarcting myocardium. Eur J Heart Fail 7:730–738
Hayashi Y, Tsuji S, Tsuji M, Nishida T, Ishii S, Lijima H, Nakamura T, Eguchi H, Miyoshi E, Hayashi N, Kawano S (2008) Topical implantation of mesenchymal stem cells has beneficial effects on healing of experimental colitis in rats. J Pharmacol Exp Ther 326:523–531
Karaoz E, Aksoy A, Ayhan S, Sariboyacı AE, Kaymaz F, Kasap M (2009) Characterization of mesenchymal stem cells from rat bone marrow: ultrastructural properties, differentiation potential and immunophenotypic markers. Histochem Cell Biol 132:533–546
Andoh A, Bamba S, Fujiyama Y, Brittan M, Wright AN (2005) Colonic subepithelial myofibroblast in mucosal inflammation and repair: contribution of bone marrow-derived stem cells to the gut regenerative response. J Gastroenterol 40:1089–1099
Tadauchi A, Narita Y, Kagami H, Niwa Y, Ueda M, Goto H (2009) Novel cell-based therapeutic strategy for ischemic colitis with use of bone marrow-derived mononuclear cells in rats. Dis Colon Rectum 52:1443–1451
Donzelli E, Salvade A, Mimo P, Vigano M, Morrone M, Papagna R, Carini F, Zaopo A, Miloso M, Baldoni M, Tredici G (2007) Mesenchymal stem cells cultured on collagen scaffold: in vitro osteogenic differentiation. Arch Oral Biol 52:64–73
Yu Y, Yao AH, Chen N, Pu LY, Fan Y, Lv L, Sun BC, Li GQ, Wang XH (2007) Mesenchymal stem cells over-expressing hepatocyte growth factor improve small-for-size liver grafts regeneration. Mol Ther 15:1382–1389
Braga LM, Lacchini S, Schaan BD, Rodriques B, Rosa K, Angelis K, Borges LF, Iriqoyen MC, Nardi NB (2008) In situ delivery of bone marrow cells and mesenchymal stem cells improves cardiovascular function in hypertensive rats submitted to myocardial infarction. J Biomed Sci 3:365–374
Hammarlund C (1999) The physiologic effects of hyperbaric oxygenation. In: Kindwall EP, Whelan HT (eds) Hyperbaric medicine practice, 2nd edn. Best, Flagstaff, pp 37–65
Friedman HF, Fitzmaurice M, Lefaivre JF, Vecchiolla TS, Clarke D (2006) An evidence-based appraisal of the use of hyperbaric oxygen on flaps and grafts. Plast Reconstr Surg 117:175–190
Machine A, Rohr S, Toti F (1999) Wound healing with hyperbaric oxygen: experimental study of the angiogenesis phase in the rat. Ann Chir 53:307–311
Gupta A, Dixit A, Sales MK, Winslet CM, Seifalian MA (2006) Tissue engineering of small intestine—current status. Biomacromolecules 7:2701–2709
Weil RB, Markel AT, Hermann LJ, Abarbanell A, Meldrum RD (2009) Mesenchymal stem cells enhance the viability and proliferation of human fetal intestinal epithelial cells following hypoxic injury via paracrine mechanisms. Surgery 146:190–197
Christensen H, Oxlund H (1994) Growth hormone increases the collagen deposition rate and breaking strength of left colonic anastomoses in rats. Surgery 116:550–556
Mast BA (1997) Healing in other tissues. Surg Clin North Am 77:529–547
Oxlund H, Christensen H, Seyer-Hansen M, Andreasses TT (1996) Collagen deposition and mechanical strength of colon anastomoses and skin incisional wounds of rats. J Surg Res 66:25–30
Dubay AD, Franz MG (2003) Acute wound healing: the biology of acute wound failure. Surg Clin N Am 83:463–481
Murohara T, Asahara T, Silver M, Bauters C, Masuda H, Kalka C, Kearney M, Chen D, Symes JF, Fishman MC, Huang PL, Isner JM (1998) Nitric oxide synthase modulates angiogenesis in response to tissue ischemia. J Clin Invest 101:2567–2578
Makela J, Ylitalo K, Lehtonen S et al (2007) Bone marrow-derived mononuclear cell transplantation improves myocardial recovery by enhancing cellular recruitment and differentiation at the infarction site. J Thorac Cardiovasc Surg 134:565–657
Phinney GD, Prockop JD (2007) Concise review: mesenchymal stem/multipotent stromal cells: the state of transdifferentiation and models of tissue repair—current views. Stem Cells 25:2896–2902
Brittan M, Chance V, Elia G, Poulsom R, Alison MR, MacDonald TT, Wright NA (2005) A regenerative role for bone marrow following experimental colitis: contribution to neovasculogenesis and myofibroblasts. Gastroenterology 128(7):1984–95
Conflicts of interest
None.
Author information
Authors and Affiliations
Corresponding author
Rights and permissions
About this article
Cite this article
Adas, G., Arikan, S., Karatepe, O. et al. Mesenchymal stem cells improve the healing of ischemic colonic anastomoses (experimental study). Langenbecks Arch Surg 396, 115–126 (2011). https://doi.org/10.1007/s00423-010-0717-z
Received:
Accepted:
Published:
Issue Date:
DOI: https://doi.org/10.1007/s00423-010-0717-z